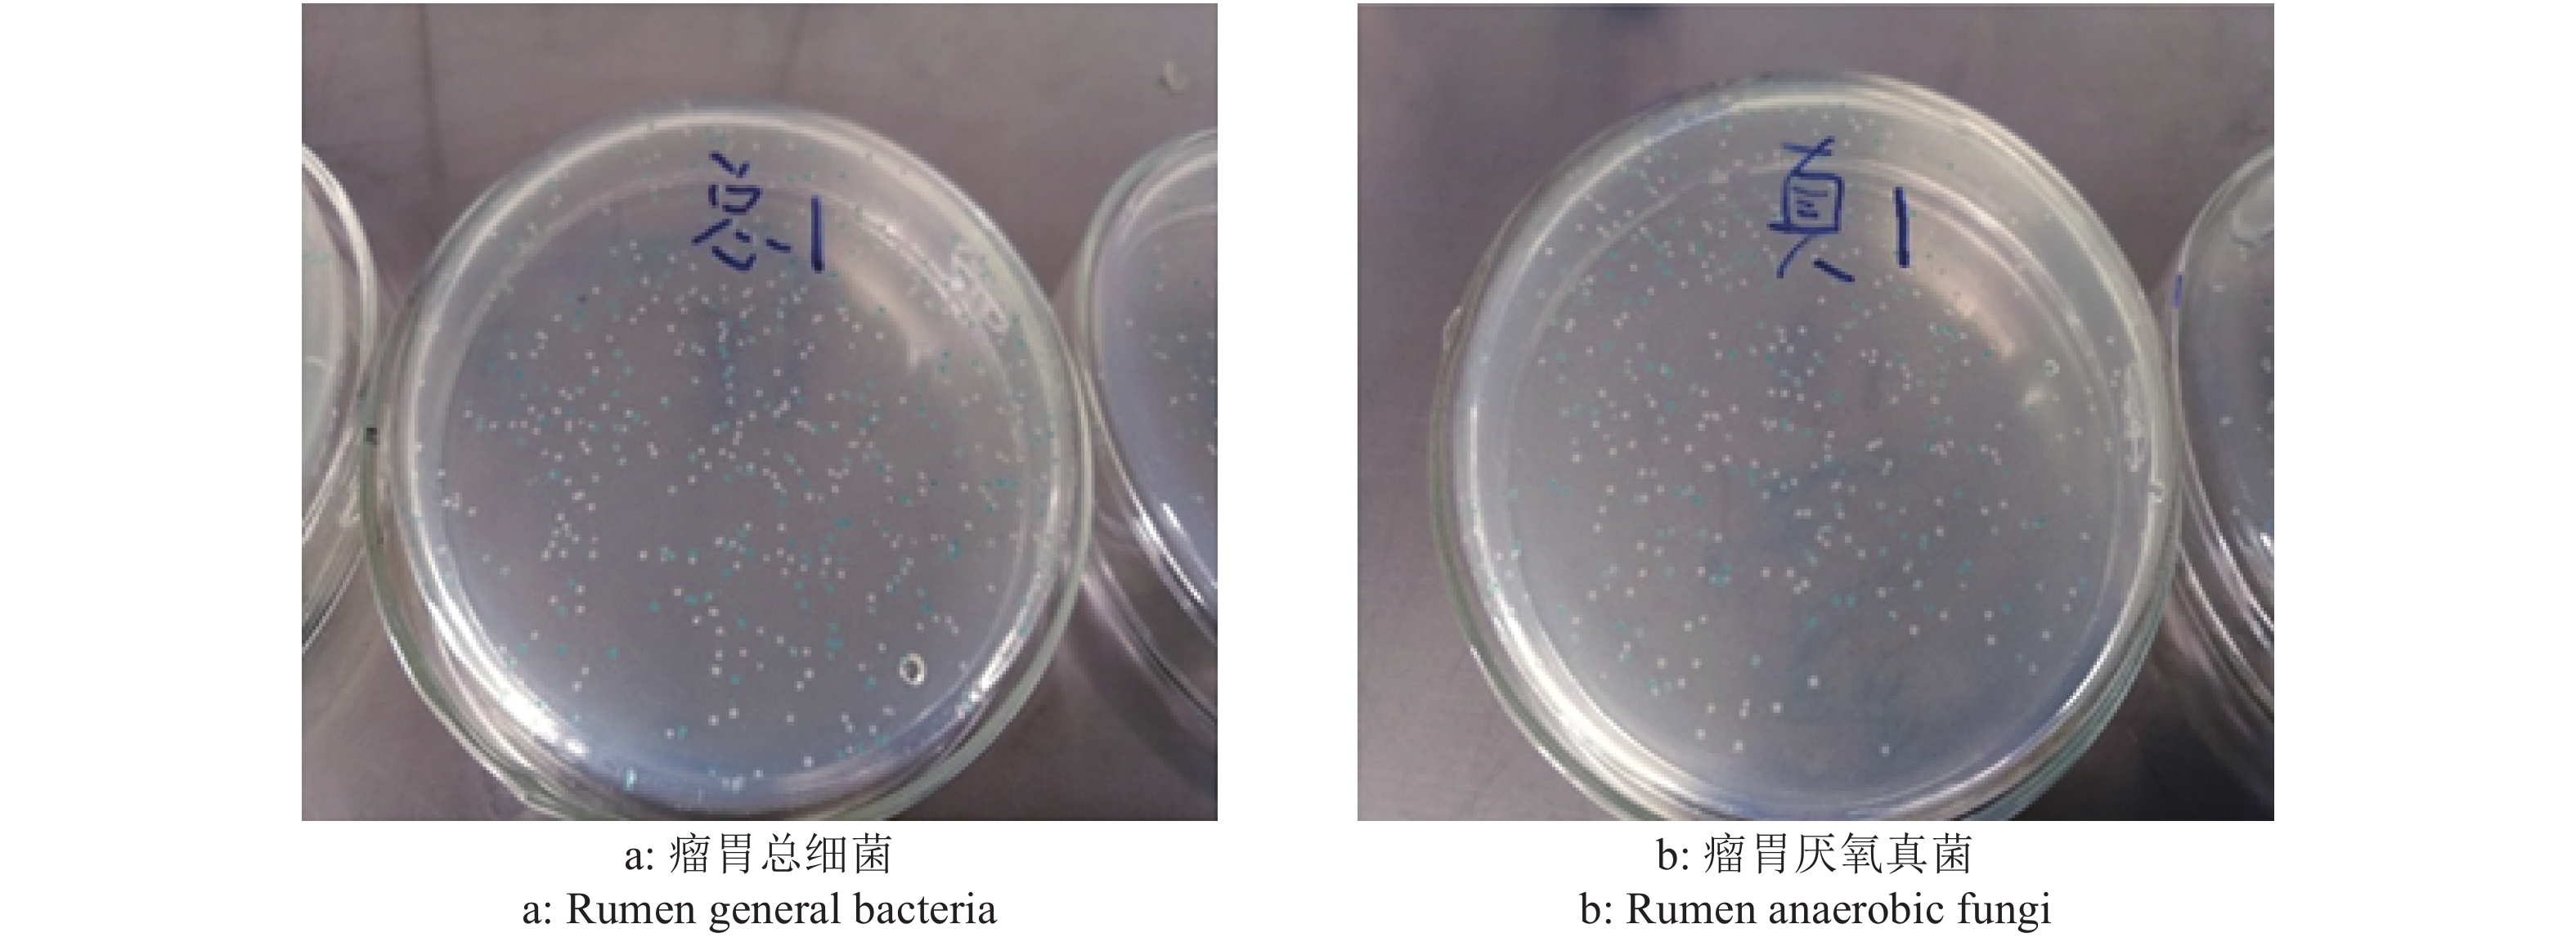

2. 金河生物科技股份有限公司,内蒙古 呼和浩特 010018;
3. 内蒙古农业大学 动物科学学院,内蒙古 呼和浩特 010018
2. Jinhe Biotechnology Co. Ltd., Hohhot 010018, China;
3. College of Animal Science, Inner Mongolia Agricultural University, Hohhot 010018, China
反刍动物瘤胃微生物系统是由细菌、古生菌、原虫和厌氧真菌共同组成的复杂微生物群落系统,瘤胃微生物对反刍动物纤维饲料的消化及转化为短链脂肪酸做出了较大贡献[1-2]。当反刍动物感染并暴发病原性细菌性疾病—如犊牛腹泻、奶牛乳房炎、羔羊痢疾及母羊流产等,注射抗生素或者口服抗生素类饲料添加剂对细菌性疾病的防治起到了相当重要的作用。但当抗生素对致病菌发挥抑制或杀灭作用的同时,对反刍动物瘤胃非病原性细菌也可能会产生杀灭或抑制作用[3],同时瘤胃微生物对口服抗生素会有一定的降解作用。
近年来,由大肠埃希菌引起的细菌性肠炎及痢疾广泛存在于反刍动物犊牛及羔羊中,每年由腹泻及痢疾造成的羔羊及犊牛死淘率给养殖业造成了巨大损失。金霉素属于广谱抗生素,具有高剂量杀菌及低剂量抑菌的效果,作为抗菌及促生长饲料添加剂在我国禽畜业养殖生产中得到了广泛使用,对养殖业发展具有重要的促进作用。前期研究发现普通金霉素预混剂颗粒在反刍动物绵羊瘤胃液中释放量较大[4],说明其对瘤胃微生物的抑制作用可能也较大。广东省兽药研制与安全评价重点实验室自主研制的反刍动物口服用金霉素微囊化颗粒在反刍动物瘤胃中的释放量比普通金霉素预混剂颗粒少,且在皱胃能够大量释放,满足反刍动物对金霉素的有效吸收,起到抑菌作用,表明其可能能够减少金霉素对瘤胃微生物的抑制作用。因此本试验将对反刍动物绵羊分别口服普通金霉素预混剂颗粒及金霉素微囊化颗粒后8种主要瘤胃微生物—瘤胃总细菌(Rumen general bacteria)、瘤胃厌氧真菌(Rumen anaerobic fungi)、白色瘤胃球菌Ruminococcus albus、黄化瘤胃球菌Ruminococcus flavefaciens、产琥珀酸拟杆菌Fibrobacter succinogens、牛链球菌Streptococcus bovis、普雷沃氏菌属Prevotellaspp.、溶纤维丁酸弧菌Butyrivibrio fibrisolvens的数量变化进行分析比较。
1 材料与方法 1.1 材料 1.1.1 药品与试剂金霉素微囊化颗粒制剂:金霉素含量为10% (w),由广东省兽药研制与安全评价重点实验室与金河生物科技股份有限公司共同研制;金霉素预混剂颗粒:金霉素含量为22.7%(w),批号20180326,由金河生物科技股份有限公司提供;PMD-19T克隆试剂盒、质粒小提试剂盒、胶回收试剂盒、RNA酶、DNA premix扩增酶、DL2000 marker、6× Loading buffer、核酸染料、TOP 10感受态细胞、荧光定量试剂盒购自宝生物工程有限公司。
1.1.2 主要仪器MAXQ4000恒温摇床和Mach 1.6R冷冻离心机购自美国赛默飞世尔科技公司;DHP-9272电热恒温培养箱购自上海一恒科技有限公司;SX-500高压锅、NanoDrop 2000酶标仪和G:BOX凝胶成像仪器购自基因有限公司;HH-2恒温水浴锅购于国华电器有限公司;CFX96 RT-PCR仪购于Bio-Rad公司。
1.1.3 培养基配制LB液体培养基:准确称取5 g酵母提取物、10 g胰蛋白胨及10 g氯化钠于1 L锥形瓶中,加入950 mL去离子水后搅拌溶解,用5 mol/L NaOH溶液调节pH为7.0后,加入去离子水定容至1 L,121 ℃条件下高压灭菌15 min,于洁净台冷却,4 ℃保存。
LB/Amp/IPTG/X-Gal固体培养基:准确称取5 g酵母提取物、10 g胰蛋白胨及10 g氯化钠于1 L锥形瓶中,加入950 mL去离子水后搅拌溶解,用5 mol/L NaOH溶液调节pH为7.0后,加入去离子水定容至1 L,121 ℃条件下高压灭菌15 min。冷却至55~60 ℃左右,加入1 mL Amp (100 mg/mL)、0.48 mL IPTG及0.80 mL X-Gal后混匀,快速倒入培养皿中,于洁净台冷却凝固,4 ℃保存。
1.1.4 试验动物体质量(29.0±2.3) kg、体况良好、6月龄左右的18只绵羊购于内蒙古呼和浩特托克托县某示范羊场。试验动物饲喂的饲粮精粗料质量比为3∶7,其中精料为内蒙古正大羊育肥料(内蒙古正大有限公司),粗料为青干草且均不含药物及抗生素。每天按照试验动物正常采食量投放精料,待精料吃完后再投放粗料。试验动物饲粮的营养水平(w)为有机物92.70%、干物质94.52%、粗蛋白质14.33%、酸性洗涤纤维24.76%、中性洗涤纤维47.30%、钙0.89%、磷0.42%。试验动物每天饲喂2次(09:00左右及17:00左右),自由饮水。羊舍环境及绵羊饲养管理均在统一试验水平条件下进行,所有试验动物均单代谢笼饲喂,且动物房保持通风。18头绵羊统一饲喂相同配比的粗精料15 d且体况均表现正常后,开始正式试验。
1.2 方法 1.2.1 试验动物与试验设计试验于2019年1月10日在内蒙古呼和浩特托克托县某示范羊场进行。所有试验动物统一饲养15 d后,随机分为6组,每组3只,包括1个空白对照组(CK)和5个给药组。空白对照组的绵羊只饲喂基础饲粮,5个给药组绵羊的具体处理如下。试验I组:饲喂基础饲粮和普通金霉素预混剂颗粒;试验II组:饲喂基础饲粮和氢化油处方组金霉素微囊化颗粒;试验III组:饲喂基础饲粮和PEG4000/单甘脂处方组金霉素微囊化颗粒,辅料PEG4000和辅料单甘脂的质量比为5︰5,试验IV组:饲喂基础饲粮和氢化油/单甘脂处方组金霉素微囊化颗粒,辅料氢化油和辅料单甘脂的质量比为9︰1;试验V组:饲喂基础饲粮和氢化油/单甘脂处方组金霉素微囊化颗粒,辅料氢化油和辅料单甘脂的质量比为8︰2。
1.2.2 给药与样本采集5个给药组按照每头绵羊的单位体质量进行灌胃给药,金霉素的给药剂量均为25 mg/kg,每天给药1次且均在晨饲前灌胃给药。连续给药5 d后对6组绵羊进行瘤胃食糜采集,采集的瘤胃食糜均迅速经4层纱布过滤,保留滤液于液氮中,−80 ℃保存。
1.2.3 瘤胃液基因组总DNA提取将瘤胃液样品从−80 ℃冰箱取出后于冰上解冻,根据李子健[5]及刘薇等[6]提供的CTAB法提取瘤胃液基因组DNA。
1.2.4 DNA的检测配制10 g/L的琼脂糖凝胶,对所提瘤胃微生物总基因组DNA进行检测,同时用酶标仪检测所提DNA的浓度及D260 nm、D280 nm值。
1.2.5 瘤胃微生物引物设计瘤胃微生物引物均在华大基因合成,引物序列见表1。
|
|
表 1 瘤胃微生物PCR扩增引物 Table 1 PCR amplification primers of ruminal microbes |
PCR预变性参数为94 ℃ 5 min;扩增参数为94 ℃ 变性30 s,55~60 ℃退火40 s,72 ℃延伸40 s,40次循环;延长参数为72 ℃ 5 min;保温温度为4 ℃。总反应体系为25 μL:DNA模板2.0 μL、上下游引物各1.0 μL、DNA聚合酶12.5 μL、灭菌超纯水8.5 μL。
1.2.7 目标片段胶回收PCR扩增产物首先用10 g/L琼脂糖凝胶进行电泳检测,目标片段合格后切胶回收。
1.2.8 PCR扩增产物的克隆连接体系连接体系为10 μL,包括胶回收产物4 μL、克隆载体1 μL 和Solution I 5 μL,于16 ℃条件下连接7 h左右。
1.2.9 PCR扩增产物的克隆阳性质粒转化将10 μL连接产物全部加入50 μL TOP 10感受态细胞中,于冰中静置30 min后转入42 ℃水浴锅中,90 s后快速转移到冰中静置2 min左右后再转至300 μL不含抗生素的LB 液体培养基,在水浴摇床中振荡培养1 h进行复苏,复苏培养条件为37 ℃、160~200 r/min。之后将复苏菌液涂布于含有抗生素及显色底物的LB固体培养基上,最后于37 ℃培养箱中培养16~20 h。
1.2.10 质粒标准品制备挑选单个白色菌落接种至含有抗生素的4 mL LB液体培养基中进行复苏培养,复苏条件为37 ℃、160~200 r/min。复苏培养12~16 h后,对菌液进行PCR阳性鉴定,鉴定为阳性者委托华大基因进行单向测序。将测序结果在NCBI比对,相似性在95%以上方可进行质粒提取。
1.2.11 荧光定量PCR标准曲线制备将质粒标准品以10倍浓度进行稀释,稀释浓度梯度不少于5个,每个梯度设置3次重复。荧光定量PCR结束后,根据荧光定量仪中的Eco软件获得质粒拷贝数与Ct值对应的线性关系,制备质粒标准曲线。
1.2.12 待测样品荧光定量分析样品和质粒标准品的PCR反应体系均为10 μL,包括模板1 μL、上下游引物各0.5 μL、灭菌超纯水3 μL、荧光定量试剂盒混合体系5 μL。各细菌RT-PCR扩增参数均与普通PCR扩增参数相同,其中熔解参数为95 ℃ 15 s,55~60 ℃ 15 s,95 ℃ 15 s。绝对定量前将待测样品统一稀释到10 ng/μL,将待测样品Ct值带入相应标准曲线得到菌群拷贝数,菌群拷贝数计算公式参考李大彪等[11]的研究。菌群数量最终采用1 mL样品中16S rDNA拷贝数的常用对数值表示。
1.2.13 数据统计分析运用SAS 9.2中GLM程序,采用Duncan’s法对荧光定量数据结果进行多重比较方差分析,差异显著性判断标准为P<0.05。
2 结果与分析 2.1 样品基因组总DNA提取结果粗提瘤胃液总DNA中,D260 nm/D280 nm值在1.8~2.0之间,质量浓度在152~897 ng/μL之间,经10 g/L琼脂糖凝胶电泳检测后,目的条带均位于2 000 bp以上,说明所提瘤胃总DNA纯度较高,浓度较大,目的条带大小正确。粗提总DNA的10 g/L琼脂糖凝胶电泳图见图1。

|
图 1 瘤胃液基因组DNA凝胶图 Fig. 1 Electrophoretogram of rumen fluid genomic DNA 1、14:DL2000 marker;2~13:瘤胃液粗提总DNA 1, 14: DL2000 marker; 2−13: Total DNA of rumen fluid crude extraction |
8种瘤胃微生物经普通PCR扩增后进行10 g/L琼脂糖凝胶电泳,检测后发现各目的条带均与预测条带一致,无非特异性扩增条带,说明可进行下一步试验。瘤胃厌氧真菌及其他7种瘤胃细菌普通PCR扩增结果见图2。

|
图 2 8种瘤胃微生物的普通PCR扩增结果 Fig. 2 Normal PCR amplification results of eight kinds of ruminal microbes 1、10:DL2000 marker,2:白色瘤胃球菌,3:牛链球菌,4:黄化瘤胃球菌,5:瘤胃厌氧真菌,6:普雷沃氏杆菌,7:溶纤维丁酸弧菌,8:瘤胃总细菌,9:产琥珀酸拟杆菌 1, 10: DL2000 marker; 2: Ruminococcus albus; 3: Streptococcus bovis; 4: Ruminococcus flavefaciens; 5: Rumen anaerobic fungi; 6: Prevotella spp.; 7: Butyrivibrio fibrisolvens; 8: Rumen general bacteria; 9: Fibrobacter succinogens |
目的基因连接转化后均匀涂布于含显色底物及Amp的固体平板培养基上,在37 ℃恒温培养箱培养16~20 h后,培养基上均长出蓝、白色单克隆菌,且单克隆菌落间界限清晰,显色明显,可进行单个白色重组质粒菌落筛选,用于下一步试验。部分目的基因蓝白筛选见图3。
|
图 3 部分目的基因蓝白筛选图 Fig. 3 White-blue plaque selection of partial target gene |
8种瘤胃微生物菌液目标条带与预测条带基本一致(图4),说明胶回收产物与克隆载体连接成功,成功构建了含有目标片段的重组质粒,可送检测序。

|
图 4 8种瘤胃微生物菌液PCR扩增 Fig. 4 Bacterial fluid PCR amplification of eight kinds of ruminal microbes 图A中,1:DL2000 marker,2、3:普雷沃氏杆菌,5:白色瘤胃球菌,6、7:溶纤维丁酸弧菌,8、9:黄化瘤胃球菌,10:牛链球菌,12、13:产琥珀酸拟杆菌;图B中,1、2、3:瘤胃总细菌,4、5、6:瘤胃厌氧真菌,7:DL2000 marker In figure A, 1: DL2000 marker; 2, 3: Prevotella spp.; 5: Ruminococcus albus; 6, 7: Butyrivibrio fibrisolvens; 8, 9: Ruminococcus flavefaciens; 10: Streptococcus bovis; 12, 13: Fibrobacter succinogens. In figure B, 1, 2, 3: Rumen general bacteria; 4, 5, 6: Rumen anaerobic fungi; 7: DL2000 marker |
将8种瘤胃微生物测序结果在NCBI(GenBank)上比对,结果显示8种瘤胃微生物目的片段序列与文库菌株相似性在95%~100%之间,表明成功构建了带有目的片段的重组质粒,能进行8种瘤胃微生物质粒标准品的制备。
2.6 重组质粒的标准曲线及扩增和熔解曲线结果8种瘤胃微生物标准曲线的相关系数均在0.99以上,且斜率在−3.75~−3.20范围内,表明拷贝数的对数值与Ct值之间呈较好的线性关系,符合荧光定量PCR反应要求;8种瘤胃微生物荧光定量PCR扩增效率在85%~105%之间,从扩增曲线可以看出均检测出了样本荧光信号。同时从熔解曲线可以看出退火温度单一,表明PCR产物特异性较强。以上结果均表明荧光定量结果符合要求,能够用于定量分析。部分图谱见图5、6、7。

|
图 5 瘤胃厌氧真菌和瘤胃总细菌标准曲线 Fig. 5 Standard curves of rumen anaerobic fungi and rumen general bacteria |

|
图 6 瘤胃厌氧真菌和瘤胃总细菌扩增曲线 Fig. 6 Amplification curves of rumen anaerobic fungi and rumen general bacteria |

|
图 7 瘤胃厌氧真菌和瘤胃总细菌熔解曲线 Fig. 7 Melt curves of rumen anaerobic fungi and rumen general bacteria |
普通金霉素预混剂颗粒和4组金霉素微囊化颗粒均会对瘤胃微生物菌群数量产生一定影响(表2)。相对于空白对照组,氢化油/单甘脂(质量比为9︰1)处方组金霉素微囊化颗粒及PEG4000/单甘脂(质量比为5︰5)处方组金霉素微囊化颗粒分别只对牛链球菌及产琥珀酸拟杆菌的数量有降低趋势(P<0.05)。普通金霉素预混剂颗粒、氢化油处方组金霉素微囊化颗粒以及氢化油/单甘脂(质量比为8︰2)处方组金霉素微囊化颗粒对多种瘤胃微生物菌群数量均有降低的趋势(P<0.05),其中普通金霉素预混剂颗粒和氢化油/单甘脂(质量比为8︰2)处方组金霉素微囊化颗粒对产琥珀酸拟杆菌及牛链球菌数量有降低趋势(P<0.05),而氢化油处方组金霉素微囊化颗粒对三大绵羊瘤胃纤维降解菌(产琥珀酸拟杆菌、白色瘤胃球菌、黄化瘤胃球菌)以及牛链球菌数量均有降低趋势(P<0.05)。因此,氢化油/单甘脂(质量比为9︰1)处方组及PEG4000/单甘脂(质量比为5︰5)处方组金霉素微囊化颗粒有相对较好的效果。
|
|
表 2 普通金霉素预混剂颗粒及4种金霉素微囊化颗粒对绵羊瘤胃微生物数量的影响 Table 2 Effects of normal chlortetracycline premix granule and four kinds of chlortetracycline microcapsules on the quantity of ruminal microbe of sheep |
与普通金霉素预混剂颗粒相比,氢化油处方组金霉素微囊化颗粒对黄化瘤胃球菌和白色瘤胃球菌的数量有更大的降低趋势(P<0.05);PEG4000/单甘脂(质量比为5︰5)处方组金霉素微囊化颗粒对溶纤维丁酸弧菌有增加趋势(P<0.05);氢化油/单甘脂(质量比为8︰2)处方组金霉素微囊化颗粒处理的各微生物菌群数量均未有明显变化;氢化油/单甘脂(质量比为9︰1)处方组金霉素微囊化颗粒显著增加了产琥珀酸拟杆菌的数量(P<0.05),对其他几种瘤胃微生物菌群数量影响均不显著(P>0.05);因此,氢化油/单甘脂(质量比为9︰1)处方组金霉素微囊化颗粒相对普通金霉素预混剂颗粒有较好的效果。
3 讨论与结论金霉素属于广谱抗生素,对大部分革兰阴性菌、革兰阳性菌、立克次体、支原体、衣原体以及阿米巴原虫等均有抑制效果。从20世纪80年代开始,饲料级金霉素就在我国作为抗菌、促生长饲料添加剂使用[12-13]。目前FDA已批准金霉素预混剂颗粒用于多种动物细菌性疾病的临床防治,其中在反刍动物临床应用中主要用于牛,治疗大肠埃希菌和沙门氏菌引起的牛细菌性肠炎,以及多杀性巴氏杆菌引起的牛细菌性肺炎,每天给药剂量约22 mg/kg,且给药时间不超过5 d,尚未批准用于治疗大肠埃希菌及沙门氏菌引起的绵羊细菌性腹泻疾病。本研究认为可能是治疗大肠埃希菌引起的绵羊腹泻所需的普通金霉素预混剂颗粒的剂量较大,绵羊口服大剂量的普通金霉素预混剂颗粒对瘤胃微生物抑制作用也较大,因此FDA暂未批准金霉素预混剂颗粒用于绵羊细菌性疾病的治疗。本试验在给药剂量及疗程上参考普通金霉素预混剂颗粒治疗由大肠埃希菌引起的牛细菌性腹泻的剂量及疗程,普通金霉素预混剂颗粒及金霉素微囊化颗粒给药剂量均定为每天25 mg/kg,给药疗程均为5 d,分析比较普通金霉素预混剂颗粒及自主研制的4种金霉素微囊化颗粒对绵羊瘤胃微生物菌群的影响。
为了降低反刍动物口服抗生素后对瘤胃微生物的影响,近年来国内开展了反刍动物口服抗生素微囊化制剂的研究试验,如反刍动物口服恩诺沙星微囊颗粒的研制[14]及过瘤胃包被恩诺沙星微丸的制备等[15],但此类研究相对较少,且国内外关于反刍动物口服金霉素微囊颗粒制剂的研究报道也较少。对于反刍动物口服普通金霉素颗粒剂对瘤胃微生物的影响,国外学者进行了大批量试验。Turner等[16]选取3头体质量在27.7~31.8 kg之间的绵羊,按每头750 mg普通盐酸金霉素颗粒(约23.6~27.1 mg/kg)的剂量口服灌胃给药,发现2 h后3头绵羊瘤胃总细菌数量均减少到了75%左右,2 d后瘤胃总细菌数量才逐渐恢复;Lodge等[17]发现长时间在饲料中按照每头肉牛240 mg/d及80 mg/d的剂量添加普通金霉素颗粒均会降低肉牛瘤胃纤维消化率;另有研究表明长时间口服普通金霉素预混剂颗粒会造成小肉牛瘤胃细菌菌群紊乱、食欲下降、个体瘤胃兼性厌氧菌增加和纤维消化细菌减少等[18]。以上研究均表明反刍动物长时间大剂量口服普通金霉素颗粒会对其瘤胃微生物菌群造成不良影响。
考虑到不同粗精比日粮对反刍动物瘤胃微生物菌群的多样性及细菌数量影响较大[19-22],为了减少试验结果误差,18头绵羊统一饲喂相同配比的粗精料15 d且体况均表现正常后,再开始正式试验。羊、牛等反刍动物能够有效消化吸收纤维类植物饲料并将其转化为自身主要能量来源,得益于反刍动物自身瘤胃微生物菌群对纤维类植物的消化降解作用,其中起主要作用的优势菌株为白色瘤胃球菌、黄化瘤胃球菌和产琥珀酸拟杆菌三大瘤胃纤维分解菌[23-24]。另外还有溶纤维丁酸弧菌[25]和牛链球菌[26-27]等绵羊瘤胃细菌以及瘤胃真菌[28]等也被证明对纤维的分解起一定作用。本试验主要研究了反刍动物口服普通金霉素预混剂颗粒及4种金霉素微囊化颗粒对瘤胃厌氧真菌及7种瘤胃细菌数量的影响。Koike等[8, 29]及Michalet-Doreau等[30]研究表明,产琥珀酸拟杆菌在3种主要瘤胃纤维分解菌中在数量上占绝对优势,比黄化瘤胃球菌和白色瘤胃球菌高1~2个数量级。本试验结果中,空白对照组绵羊产琥珀酸拟杆菌、黄化瘤胃球菌和白色瘤胃球菌数量的数量级分别为1010、109和108,产琥珀酸拟杆菌数量分别比黄化瘤胃球菌和白色瘤胃球菌数量高1~2个数量级,与前期研究结果一致,证实了本试验定量结果的真实准确性。在普通金霉素预混剂颗粒和4组金霉素微囊化颗粒对瘤胃微生物数量影响的研究中,与空白对照组相比,普通金霉素预混剂颗粒组和4种金霉素微囊化颗粒组绵羊的瘤胃总细菌、瘤胃真菌以及普雷沃氏菌属数量均未发生显著变化(P>0.05),其中瘤胃总细菌的数量变化与Munch-Petersen等[18]在饲料中加入普通金霉素预混剂颗粒后瘤胃总细菌数量增加的结果有所不同。
普通金霉素预混剂颗粒及4种金霉素微囊化颗粒均或多或少使瘤胃微生物数量产生变化,但相对于普通金霉素预混剂颗粒和其他3种金霉素微囊化颗粒,氢化油/单甘脂(质量比为9︰1)处方组金霉素微囊化颗粒对绵羊瘤胃微生物数量的抑制作用较小。因此本试验结果可为金霉素微囊化颗粒制剂处方的进一步筛选提供科学合理的数据,同时也能为下一步临床试验研究提供参考。
| [1] |
ROSS E M, PETROVSKI S, MOATE P J, et al. Metagenomics of rumen bacteriophage from thirteen lactating dairy cattle[J]. BMC Microbiology, 2013, 13(1): 242. doi: 10.1186/1471-2180-13-242.
(  0) 0) |
| [2] |
KIM M, MORRISON M, YU Z. Status of the phylogenetic diversity census of ruminal microbiomes[J]. FEMS Microbiology Ecology, 2011, 76(1): 49-63. DOI:10.1111/j.1574-6941.2010.01029.x (  0) 0) |
| [3] |
李伟. β−内酰胺类抗生素有抗奶对犊牛瘤胃菌群结构及生长影响的研究[D]. 大庆: 黑龙江八一农垦大学, 2017.
(  0) 0) |
| [4] |
黄显会, 胡浪, 李国基. 一种用于反刍动物口服的金霉素微囊化颗粒及其制备方法: CN109528681A[P]. 2019-03-29.
(  0) 0) |
| [5] |
李子健. 不同生理阶段奶牛瘤胃细菌菌群数量与多样性的比较研究[D]. 呼和浩特: 内蒙古农业大学, 2018.
(  0) 0) |
| [6] |
刘薇, 方国庆, 刘立成, 等. 奶牛瘤胃微生物DNA提取法的研究与优化[J]. 中国畜牧杂志, 2011, 47(13): 71-75. (  0) 0) |
| [7] |
DENMAN S E, MCSWEENEY C S. Development of a real-time PCR assay for monitoring anaerobic fungal and cellulolytic bacterial populations within the rumen[J]. FEMS Microbiology Ecology, 2006, 58(3): 572-582. DOI:10.1111/j.1574-6941.2006.00190.x (  0) 0) |
| [8] |
KOIKE S, KOBAYASHI Y. Development and use of competitive PCR assays for the rumen cellulolytic bacteria: Fibrobacter succinogenes, Ruminococcus albusand Ruminococcus flavefaciens
[J]. FEMS Microbiology Letters, 2001, 204(2): 361-366. DOI:10.1111/j.1574-6968.2001.tb10911.x (  0) 0) |
| [9] |
FERNANDO S C, PURVIS H T, NAJAR F Z, et al. Rumen microbial population dynamics during adaptation to a high-grain diet[J]. Applied and Environmental Microbiology, 2010, 76(22): 7482-7490. DOI:10.1128/AEM.00388-10 (  0) 0) |
| [10] |
COBELLIS G, YU Z, FORTE C, et al. Dietary supplementation of Rosmarinus officinalis L. leaves in sheep affects the abundance of rumen methanogens and other microbial populations[J]. Journal of Animal Science and Biotechnology, 2016, 7. doi: 10.1186/s40104-016-0086-8.
(  0) 0) |
| [11] |
李大彪, 张梅梅, 于永强, 等. 单宁和聚乙二醇对绵羊和山羊瘤胃纤维降解菌数量的影响[J]. 动物营养学报, 2015, 27(2): 596-605. DOI:10.3969/j.issn.1006-267x.2015.02.032 (  0) 0) |
| [12] |
伍涛, 杨旭, 李书至. 金霉素在畜牧业中的应用概述[J]. 四川畜牧兽医, 2015, 42(10): 35-36. DOI:10.3969/j.issn.1001-8964.2015.10.014 (  0) 0) |
| [13] |
伍涛, 郭红伟, 李书至. 饲料级金霉素研究进展[J]. 中国动物保健, 2014, 16(12): 18-20. DOI:10.3969/j.issn.1008-4754.2014.12.007 (  0) 0) |
| [14] |
马立保, 李梦超, 黄敏, 等. 一种用于反刍动物口服的恩诺沙星微囊及其制备方法: CN106176667A[P]. 2016-12-07.
(  0) 0) |
| [15] |
靳茹文, 严根文, 林芝. 一种过瘤胃包被恩诺沙星微丸及其制备方法: CN105106175A[P]. 2015-12-02.
(  0) 0) |
| [16] |
TURNER A W, HODGETTS V E. Depression of ruminal digestion in adult sheep by aureomycin[J]. Australian Journal of Agricultural Research, 1952, 3(4): 453-459. DOI:10.1071/AR9520453 (  0) 0) |
| [17] |
LODGE J R, MILES J T, JACOBSON N L, et al. Influence of chlortetracycline on in vitro cellulose digestion by bovine rumen microorganisms[J]. Journal of Dairy Science, 1956, 39(3): 303-311. DOI:10.3168/jds.S0022-0302(56)94749-X (  0) 0) |
| [18] |
MUNCH-PETERSEN E, ARMSTRONG J. The influence of orally administered oxytetracycline on the rumen bacteria of sheep[J]. The Australian Journal of Experimental Biology and Medical Science, 1958, 36(1): 77-82. DOI:10.1038/icb.1958.9 (  0) 0) |
| [19] |
MAO S Y, ZHANG R Y, WANG D S, et al. Impact of subacute ruminal acidosis (SARA) adaptation on rumen microbiota in dairy cattle using pyrosequencing[J]. Anaerobe, 2013, 24: 12-19. DOI:10.1016/j.anaerobe.2013.08.003 (  0) 0) |
| [20] |
VAREL V H, DEHORITY B A. Ruminal cellulolytic bacteria and protozoa from bison, cattle-bison hybrids, and cattle fed three alfalfa-corn diets[J]. Applied and Environmental Microbiology, 1989, 55(1): 148-153. DOI:10.1128/AEM.55.1.148-153.1989 (  0) 0) |
| [21] |
杨宏波, 刘红, 占今舜, 等. 不同精粗比颗粒饲料对断奶公犊牛瘤胃发酵参数和微生物的影响[J]. 草业学报, 2015, 24(12): 131-138. DOI:10.11686/cyxb2015022 (  0) 0) |
| [22] |
林波, 梁辛, 李丽莉, 等. 饲粮精粗比对泌乳水牛瘤胃细菌和甲烷菌区系的影响[J]. 动物营养学报, 2016, 28(10): 3101-3109. DOI:10.3969/j.issn.1006-267x.2016.10.012 (  0) 0) |
| [23] |
王超, 刘国道. 瘤胃微生物降解纤维素的研究进展[J]. 安徽农业科学, 2007, 35(13): 3771-3772. DOI:10.3969/j.issn.0517-6611.2007.13.002 (  0) 0) |
| [24] |
WINDHAM W R, AKIN D E. Rumen fungi and forage fiber degradation[J]. Applied and Environmental Microbiology, 1984, 48(3): 473-476. DOI:10.1128/AEM.48.3.473-476.1984 (  0) 0) |
| [25] |
HESPELL R B, WOLF R, BOTHAST R J. Fermentation of xylans by Butyrivibrio fibrisolvensand other ruminal bacteria
[J]. Applied and Environmental Microbiology, 1987, 53(12): 2849-2853. DOI:10.1128/AEM.53.12.2849-2853.1987 (  0) 0) |
| [26] |
那仁图雅, 周非帆, 杨金丽, 等. 绵羊瘤胃内纤维降解菌的分离鉴定[J]. 中国畜牧兽医, 2014, 41(5): 142-146. (  0) 0) |
| [27] |
王卫云, 李大彪, 于永强, 等. 瘤胃4株纤维降解细菌的分离鉴定及其纤维降解特性[J]. 畜牧兽医学报, 2016, 47(11): 2294-2300. DOI:10.11843/j.issn.0366-6964.2016.11.018 (  0) 0) |
| [28] |
王全军, 朱伟云. 瘤胃微生物及其在饲料工业中的应用前景[J]. 动物科学与动物医学, 2000, 17(3): 64-66. (  0) 0) |
| [29] |
KOIKE S, PAN J, KOBAYASHI Y, et al. Kinetics of in sacco fiber-attachment of representative ruminal cellulolytic bacteria monitored by competitive PCR[J]. Journal of Dairy Science, 2003, 86(4): 1429-1435. DOI:10.3168/jds.S0022-0302(03)73726-6 (  0) 0) |
| [30] |
MICHALET-DOREAU B, FERNANDEZ I, FONTY G. A comparison of enzymatic and molecular approaches to characterize the cellulolytic microbial ecosystems of the rumen and the cecum[J]. Journal of Animal Science, 2002, 80(3): 790-796. DOI:10.2527/2002.803790x (  0) 0) |
 2021, Vol. 42
2021, Vol. 42


